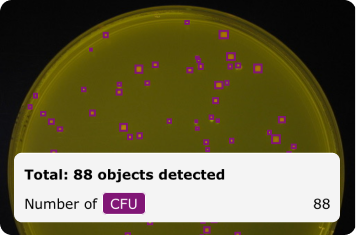
Cell Colony Counting
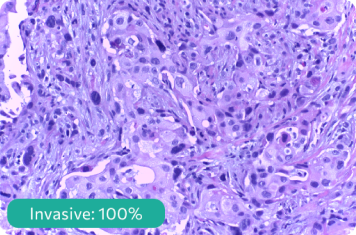
Histopathology and Cancer Detection

Computer Vision in Life Sciences
In the life sciences industry, precision is paramount. From microscopic irregularities to incomplete sample preparations, every detail can impact patient outcomes and research findings.
Empower your research and quality control processes in the life sciences with LandingAI. Use LandingLens, our AI-powered cloud-based computer vision platform, to quickly train and deploy models.
Elevate your standards, improve patient outcomes, enhance research accuracy, and achieve unparalleled success
throughout your laboratory using Artificial Intelligence in the life sciences industry.
AI Applications in Life Sciences
Cell Colony Counting
Automate the counting of cell colonies in microscopic images with LandingLens. Save time, prevent manual error and observer bias, and accelerate research and drug discovery.
Histopathology and Cancer Detection
Analyze tissue samples and quickly detect anomalies like cancerous regions with LandingLens. Clinicians can use LandingLens as a tool to effectively diagnose diseases and improve patient outcomes.

Cell Segmentation
Automatically identify and delineate individual cells within microscopic images, allowing researchers to effectively analyze the properties and behaviors of individual cells within a sample.

Detect and Diagnose in Medical Imaging
Enhance the accuracy of MRI, CT, PET, X-ray, and ultrasound image analysis by training models in LandingLens to detect abnormalities. LandingLens can review thousands of images looking for anomalies or diagnostic mismatches that deserve further investigation.

Diagnose Stages of Disease
In addition to detecting whether or not a disease or condition is present, models from LandingLens can also determine how advanced a condition is. For example, LandingLens can be trained to classify stages of knee osteoarthritis (OA).

Detect Defective Tablets and Capsules
Detect and identify defective tables, pills, and capsules with computer vision models from LandingLens. Protect consumers, comply with regulations, and save costs by automating quality control with LandingLens.
Leverage Your Data in Snowflake
Already have your images in Snowflake? LandingLens is available in the Snowflake Marketplace! This means that LandingLens can directly access the images that you already have stored in Snowflake.
Additionally, you can do it all within the secure, governed boundary of the Data Cloud!

